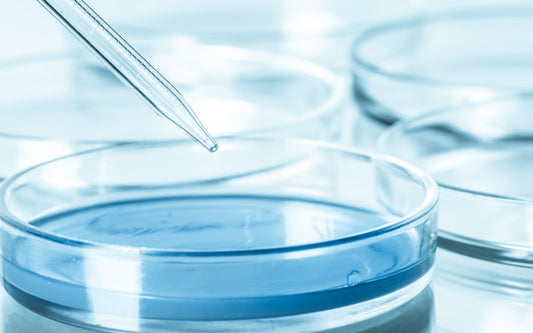

Bienvenidos al Blog de Alkanatur
En el blogAlkanatur Chilepodrás encontrar artículos interesantes sobre los beneficios de beber agua alcalina, investigaciones científicas acerca de nuestro producto, recetas y consejos de cómo llevar una vida más saludable y mucho más. Nuestro objetivo es generar una mayor consciencia sobre la importancia de tener y mantener un cuerpo el equilibrio.
Blog

Dra. Elizabeth Hubach: “El agua alcalina nos ay...
Luego de enfrentar una enfermedad personal, la doctora Elizabeth Hubach se cambió del mundo de la medicina tradicional a la medicina biológica, en donde descubrió la importancia del agua como...
Dra. Elizabeth Hubach: “El agua alcalina nos ay...
Luego de enfrentar una enfermedad personal, la doctora Elizabeth Hubach se cambió del mundo de la medicina tradicional a la medicina biológica, en donde descubrió la importancia del agua como...

3 Recetas de postres beneficiosos para tu salud
Cuando pensamos en postres, generalmente pensamos en cosas que vienen con azúcares añadidas y grasas saturadas, que son perjudiciales para nuestra salud. Por eso tenemos la creencia de que hacen...
3 Recetas de postres beneficiosos para tu salud
Cuando pensamos en postres, generalmente pensamos en cosas que vienen con azúcares añadidas y grasas saturadas, que son perjudiciales para nuestra salud. Por eso tenemos la creencia de que hacen...

¿Qué nos enseñó Zac Efron sobre el agua en down...
En el segundo capítulo de la serie de Netflix “Con los pies en la tierra”, el actor asiste a una actividad con un sommelier de agua y se sorprende por...
¿Qué nos enseñó Zac Efron sobre el agua en down...
En el segundo capítulo de la serie de Netflix “Con los pies en la tierra”, el actor asiste a una actividad con un sommelier de agua y se sorprende por...
Estudios Científicos Sobre Los Beneficios Del A...
El consumo de la dieta occidental, caracterizada principalmente por ser rica en grasas de origen animal y azucares simples así como pobre en fibra, frutas y verduras, se ha relacionado con...
Estudios Científicos Sobre Los Beneficios Del A...
El consumo de la dieta occidental, caracterizada principalmente por ser rica en grasas de origen animal y azucares simples así como pobre en fibra, frutas y verduras, se ha relacionado con...

Combatir toxinas tomando agua de calidad- Sophi...
Hoy más que nunca estamos en constante exposición a toxinas ambientales, que la mayoría del tiempo, no podemos evitar. Es difícil identificar de qué toxinas se trata, pero están presentes...
Combatir toxinas tomando agua de calidad- Sophi...
Hoy más que nunca estamos en constante exposición a toxinas ambientales, que la mayoría del tiempo, no podemos evitar. Es difícil identificar de qué toxinas se trata, pero están presentes...

¿Cómo Eliminar Trihalometanos En El Agua Del Gr...
Luego de que el estudio publicado en enero de este año haya disparado las alarmas al surgir una relación entre el cáncer de vejiga y el consumo de agua de la red...
¿Cómo Eliminar Trihalometanos En El Agua Del Gr...
Luego de que el estudio publicado en enero de este año haya disparado las alarmas al surgir una relación entre el cáncer de vejiga y el consumo de agua de la red...



